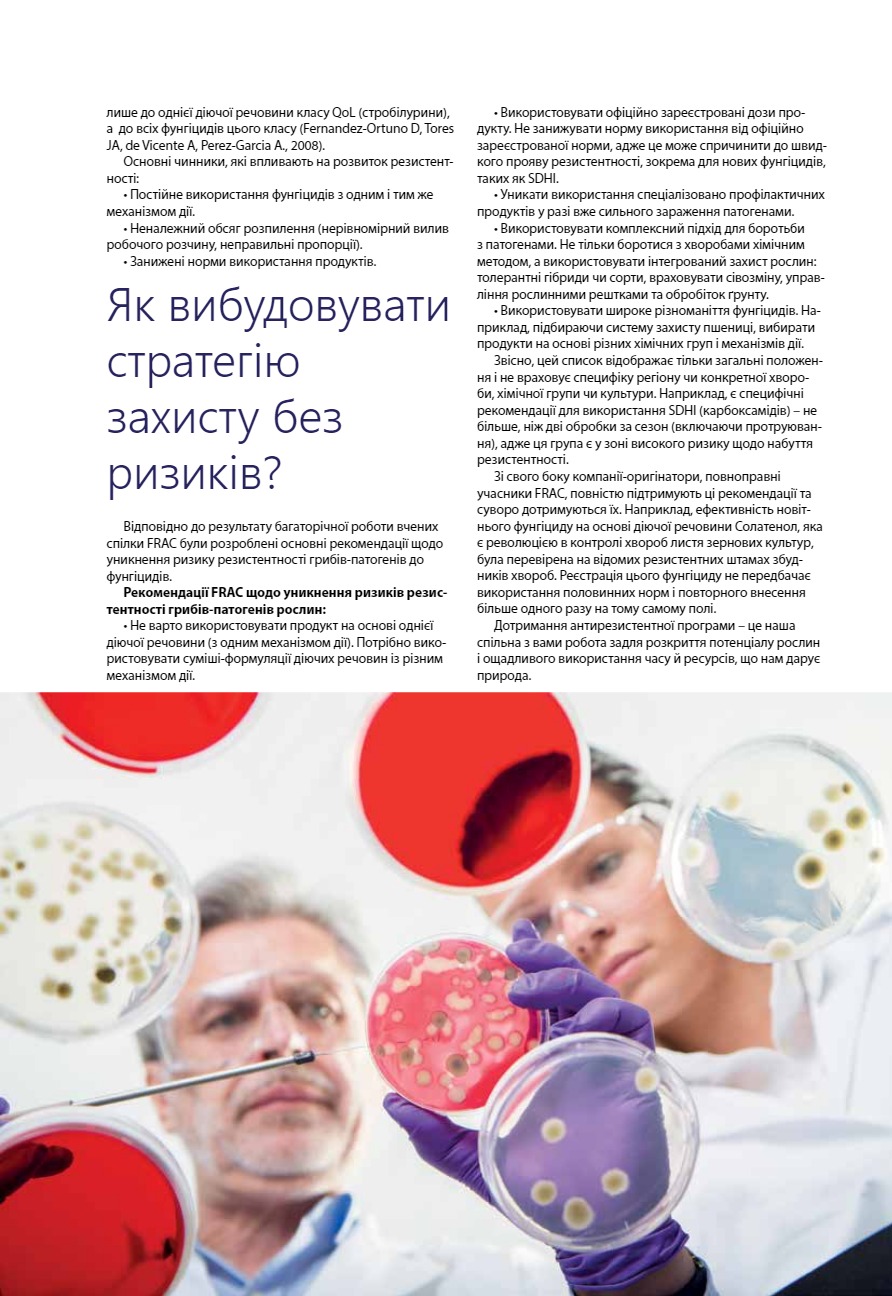

Читайте в номері:
НОВИНИ
IV Міжнародний конгрес «Органічна Україна 2020». Онлайн-формат
АКТУАЛЬНО
Ринок землі? Прийнято… як відкладений старт вплине на економіку
РОСЛИННИЦТВО
ФГ «Бізон-1» та «Сервіс-Агрозахід»: співпраця на результат
IV Міжнародний конгрес «Органічна Україна 2020»: конспект свідомого аграрія
Професійне управління ростом рослин із Моддус® навесні 2020-го
Ситуація на полях: нестандартні умови – нестандартні рішення
Резистентність грибів-патогенів рослин. Управління ризиками
Як зменшити вплив негативних чинників і збільшити врожайність
Урожайність і цукристість коренеплодів цукрового буряка залежно від листкового підживлення
Догляд за озимим ріпаком у весняно-літній сезон
Розумне застосування гербіцидів
ТЕХНІКА
Новітні рішення у захисті рослин. Обприскувачі
Аплікатор для внесення рідких добрив у ґрунт
Як боролися проти Iнтернету речей у сільському господарстві
ТВАРИННИЦТВО
Органічне тваринництво без профілактичних антибіотиків
АГРОІСТОРИК
Петро Прокопович – винахідник сучасного способу бджільництва
Залишити коментар: